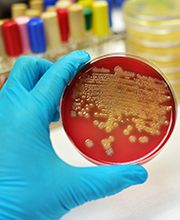
Gallery Cliente

La Bottega dei Sapori di Ponticelli Antonello SAS
Supermercato · Vendita al dettaglio · Banco dei formaggi
Via Nicola Nicolini 51, 80141 NapoliRicerca
+390817514123 (Telefono)
Il Laboratorio analisi S. Giuseppe nasce nel 1970 opera nel territorio della ASL NA1 distretto sanitario 49. La lunga storia del laboratorio che ha iniziato la sua attività nel periodo degli albori di questo settore. riportiamo sotto solo alcuni dei numerosi strumenti che fanno parte della nostra storia. Nel corso degli anni il laboratorio si è evoluto sempre seguendo l'evoluzioni della tecnologia. attualmente è dotato di strumentazioni completamente automatiche ed un sistema informatico interfacciato con gli analizzatori automatici.
Via Nicola Nicolini, 39, 80141 Napoli
Supermercato · Vendita al dettaglio · Banco dei formaggi
Via Nicola Nicolini 51, 80141 Napoli